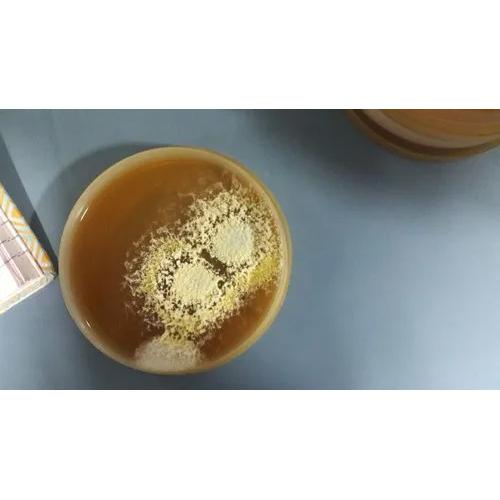
हाइजीन ऑडिट बायोबर्डन स्वाब टेस्टिंग सर्विस

हाइजीन ऑडिट बायोबर्डन स्वाब टेस्टिंग सर्विस
नवीनतम कीमत पता करेंPrice
Get Best Deals
| मटेरियल | Sterile medical-grade swab and transport medium |
| साइज | Standard swab stick; suitable for surface swabbing |
| वज़न | Lightweight; approx. 5g per test kit |
| उपयोग/अनुप्रयोग | Detection and quantification of microbial bioburden for hygiene audits in food, pharma, and healthcare industries |
| अंतरफलक | Manual swabbing with laboratory processing |
विस्तृत जानकारी
| मटेरियल | Sterile medical-grade swab and transport medium |
| साइज | Standard swab stick; suitable for surface swabbing |
| वज़न | Lightweight; approx. 5g per test kit |
| उपयोग/अनुप्रयोग | Detection and quantification of microbial bioburden for hygiene audits in food, pharma, and healthcare industries |
| अंतरफलक | Manual swabbing with laboratory processing |
| तापमान | Recommended storage and usage between 2°C to 25°C |
| चालित प्रकार | Manual |
| डिसप्ले | Lab analysis report (no direct digital display) |
| मापने की सीमा | 1-10,000 CFU/swab, depending on sample and protocol |
कंपनी का विवरण
ेलशद्दै आराधना ग्रुप इनोवेटिव बिज़नेस सोलूशन्स, 2015 में महाराष्ट्र के पुणे में स्थापित, भारत में विश्लेषणात्मक परीक्षण प्रयोगशालाएँ का टॉप सेवा प्रदाता है। ेलशद्दै आराधना ग्रुप इनोवेटिव बिज़नेस सोलूशन्स, ट्रेड इंडिया के सूचीबद्ध सेवाओं के लिए के सत्यापित और विश्वसनीय नामों में से एक है। विश्लेषणात्मक परीक्षण प्रयोगशालाएँ के क्षेत्र में अपने व्यापक अनुभव के साथ, ेलशद्दै आराधना ग्रुप इनोवेटिव बिज़नेस सोलूशन्स ने उच्च गुणवत्ता आदि के साथ बाजार में अपने लिए एक प्रतिष्ठित नाम बनाया है। ग्राहक केंद्रित दृष्टिकोण पर ध्यान केंद्रित करते हुए, ेलशद्दै आराधना ग्रुप इनोवेटिव बिज़नेस सोलूशन्स की अखिल भारतीय उपस्थिति है और पूरे देश में एक विशाल उपभोक्ता आधार को पूरा करता है। ट्रेड इंडिया गुणवत्ता-सुनिश्चित सेवाओं पर ेलशद्दै आराधना ग्रुप इनोवेटिव बिज़नेस सोलूशन्स से विश्लेषणात्मक परीक्षण प्रयोगशालाएँ सेवाएं प्राप्त करें। ग्राहक केंद्रित दृष्टिकोण पर ध्यान केंद्रित करते हुए, ेलशद्दै आराधना ग्रुप इनोवेटिव बिज़नेस सोलूशन्स की अखिल भारतीय उपस्थिति है और पूरे देश में एक विशाल उपभोक्ता आधार को पूरा करता है। ट्रेड इंडिया गुणवत्ता-सुनिश्चित सेवाओं पर ेलशद्दै आराधना ग्रुप इनोवेटिव बिज़नेस सोलूशन्स से विश्लेषणात्मक परीक्षण प्रयोगशालाएँ सेवाएं प्राप्त करें।
व्यापार के प्रकार
निर्माता, सेवा प्रदाता, आपूर्तिकर्ता, व्यापार कंपनी
कर्मचारी संख्या
10
स्थापना
2015
कार्य दिवस
सोमवार से रविवार
जीएसटी सं
27AWPPK8647L1ZL
भुगतान का प्रकार
ऑनलाइन भुगतान (एनईएफटी/आरटीजीएस/आईएमपीएस), चेक/डीडी, वॉलेट और यूपीआई, नकद
Explore in english - Hygiene Audit Bioburden Swab Testing Service
विक्रेता विवरण
ेलशद्दै आराधना ग्रुप इनोवेटिव बिज़नेस सोलूशन्स
जीएसटी सं
27AWPPK8647L1ZL
नाम
अभिजीत कुम्भार
पता
स र नो.२८२/८९ लक्समी कॉलोनी नियर गणेश टेम्पल हडपसर सोलपुर रोड पुणे, महाराष्ट्र, 411028, भारत
गलत विवरण की रिपोर्ट करें
































